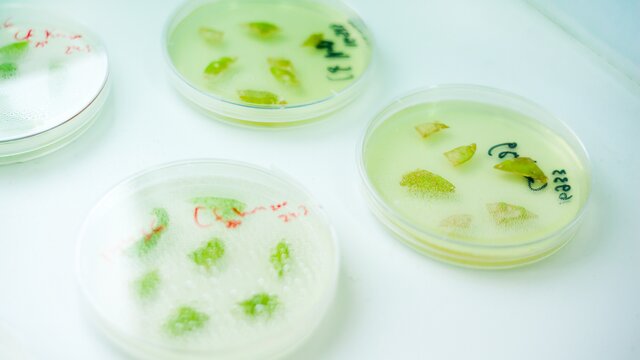

Digital October
22 февраля 2017
-
 Встреча с Аленой Долецкой – главредом Interview
Встреча с Аленой Долецкой – главредом Interview
17:27

-
 Как новые технологии меняют наш мир
Как новые технологии меняют наш мир
17:03

-
15:49

16 февраля 2017
14 февраля 2017
-
 "Мослекторий" покажет, как люди превращаются в киборгов
"Мослекторий" покажет, как люди превращаются в киборгов
18:19

-
 "Мослекторий" покажет, что такое поколение Z
"Мослекторий" покажет, что такое поколение Z
17:51

-
 "Мослекторий" покажет встречу с Аленой Долецкой – главредом Interview
"Мослекторий" покажет встречу с Аленой Долецкой – главредом Interview
16:04

19 января 2017
07 октября 2016
17 июня 2016
14 июня 2016
27 мая 2016
18 марта 2016
22 декабря 2015
-
 Создатель "Клаустрофобии" – об успехе квестов в реальности
Создатель "Клаустрофобии" – об успехе квестов в реальности
15:50

-
 "Инфотейнмент: смерть журналистики или новое рождение"
"Инфотейнмент: смерть журналистики или новое рождение"
15:22

-
 Red Apple: дискуссия "Маркетинг для людей"
Red Apple: дискуссия "Маркетинг для людей"
14:58

17 декабря 2015
11 декабря 2015
10 декабря 2015
09 декабря 2015
-
15:40

07 декабря 2015
29 сентября 2015
-
 Как делаются шоу, где главные действующие лица – зрители
Как делаются шоу, где главные действующие лица – зрители
12:10

-
12:09

-
12:00

17 сентября 2015








 Собянин: с 20:00 силами ПВО только на подлете к Москве уничтожен 61 БПЛА
Собянин: с 20:00 силами ПВО только на подлете к Москве уничтожен 61 БПЛА